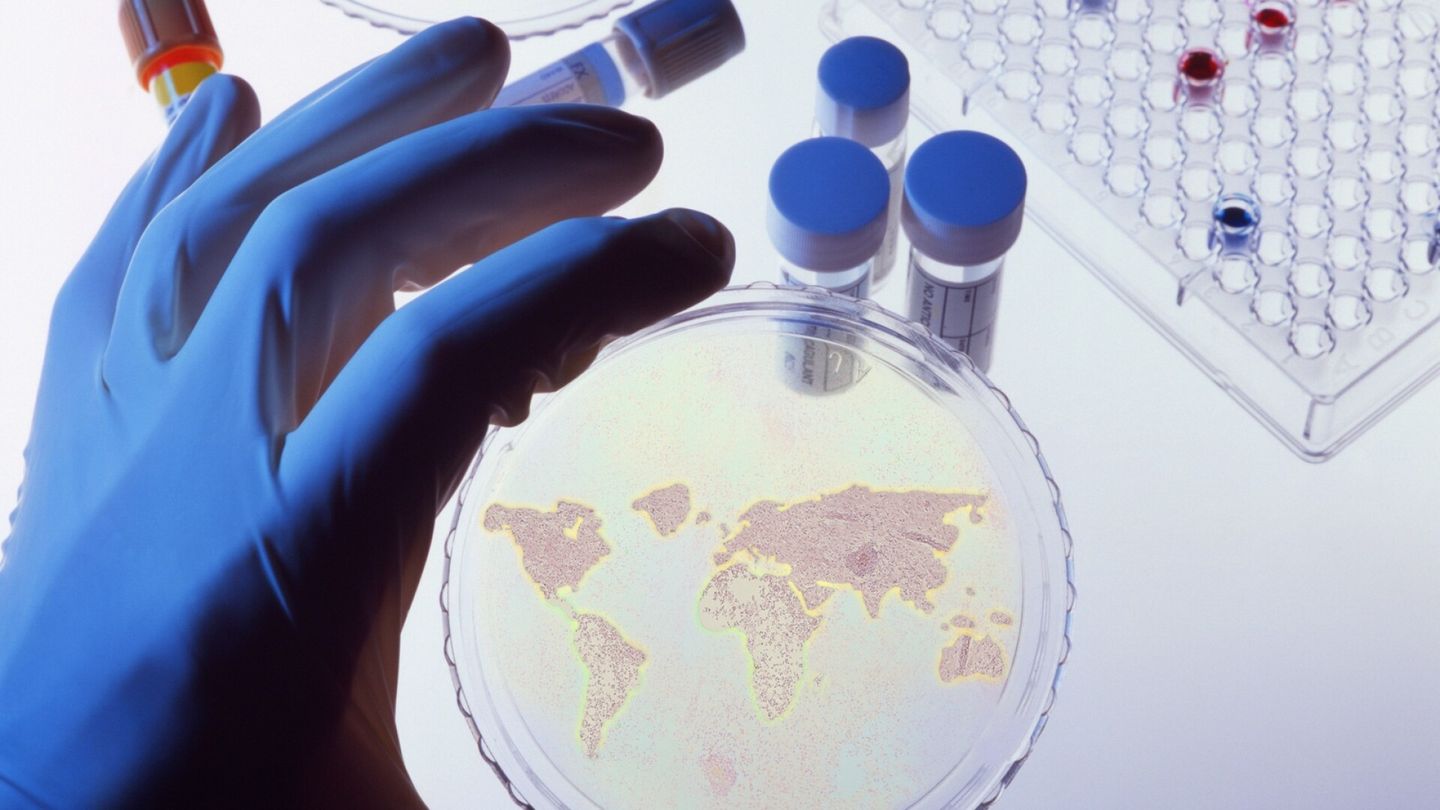
Kuva

Bioaseet | Voisiko viruksia todella räätälöidä täsmäaseiksi?
Supo on varoittanut, että terveystietoja voidaan yrittää käyttää taudinaiheuttajien kehittämiseen. Osumatarkkuus olisi aika heikkoa, arvioi professori.
Lue alkuperäinen uutinen osoitteessa https://www.hs.fi/tiede/art-2000011235930.html


